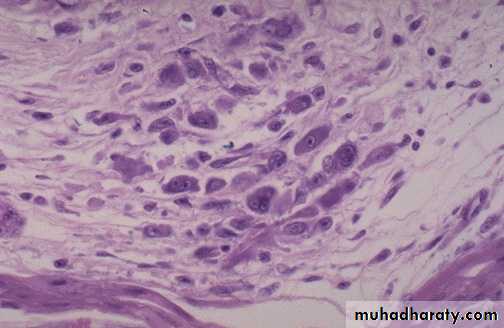
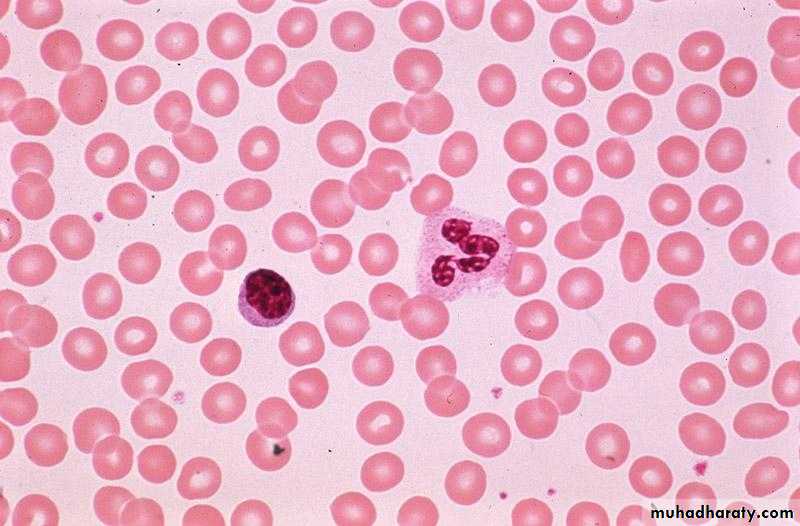
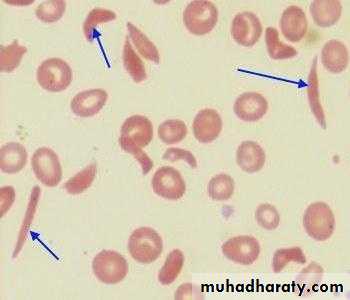
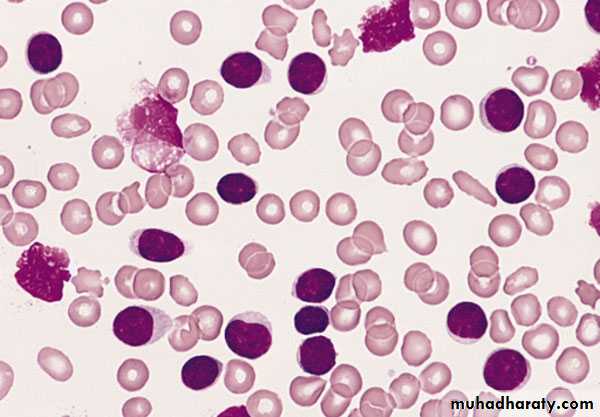

باثو عملي .. الفصل الثاني
Cardiovascular diseases
طب الاسنانLeft sided heart failure, Pulmonary congestion with dilated capillaries and leakage of blood into alveolar spaces leads to an increase in hemosiderin-laden macrophages ( heart failure cells)
heart failure cell
Acute M.I (1-2) days: necrosis of myocardial cells with a dark red contraction band necrosis extending along it, in addition to neutrophils infiltrationIntermediate M.I with 1-2 weeks age: there are remaining normal myocardial fibers at the top. Below these fibers are many macrophages along with numerous capillaries and little collagenization (granulation tissue)
There is pale white collagen within the interstitium between myocardial fibers. This represents an area of remote (old) infarction
A cross section through the heart demonstrates the left ventricle on the left with a large myocardial infarction. The center is tan with surrounding hyperemia. The infarction is "transmural" in that it extends through the full thickness of the wall.
Acute infective endocarditis: Irregular reddish tan destructive vegetations overlie valve cusps that are being destroyed. Portions of the vegetation can break off and become septic emboli.
Aschoff nodules of acute rheumatic carditis: acute rheumatic carditis is marked by a granulomatous inflammation "Aschoff nodules" seen in myocardium around vessel.
Aschoff nodules at high magnification : The most characteristic component is the antiskow’s cell & Aschoff giant cell. They are large cells with two or more nuclei that have prominent nucleoli, with scattered inflammatory cells
Chronic rheumatic mitral stenosis (fish-mouth shape) due to fibrosis & scarring.Diagnosis: remote complication of rheumatic heart disease
A wall of normal blood vessel
The coronary artery shown here has narrowing of the lumen due to build up of atherosclerotic plaque. Severe narrowing can lead to angina, ischemia, and infarction. At the right : Atheroma is complicated by calcification (arrow)
Atheroma at high magnification : numerous foam cells & cholesterol clefts extracellular lipid material with few inflammatory cells.
Atheroma with numerous cholesterol clefts. Note the ulceration & hemorrhage at the surfaceDiagnosis: complicated atheroma
Atherosclerotic aneurysm
large fusiform"bulge" appears just above the aortic bifurcation of the common iliac arteries.Such aneurysms are prone to rupture when they reach about 6 to 7 cm in size.
B- histology of capillary hemangioma
A- a mass well circumscribe, dark red in color on the right side of the tongue
Diagnosis: Hemangioma of the tongueC-histology of cavernous
hemangioma.
Pyogenic granuloma is a small bright red, glistening bump that typically appears on the face, arms, or hands. It typically has a thin, white border. They may bleed profusely, ulcerate or become crusty, but most are shiny, red, bead-like bump
Practical hemodynamic disturbances
Congestion of the liver (due to Rt. sided heart failure), the dark red congested regions that represent accumulation of RBC's in centrilobular regions with the surrounding viable parenchyma forming a "nutmeg" liver
Microscopical slide of the liver, the central vein and sinusoids are distended with blood with central hepatocyte degeneration; This is usually due to a "right sided" heart failure. Diagnosis: liver congestion
Two oval shape thrombus attached to the wall of right atrial with clear lamination (lines of Zahn)diagnosis: mural thrombus in the heart
The deep vein of the leg contain thrombus which has apparent laminations (lines of Zahn), produced by alternating pale layers of platelets admixed with some fibrin and darker layers containing more red blood cells. Diagnosis : Deep venous thrombosis
These are "lines of Zahn" which are the alternating pale layers of platelets admixed with fibrin and darker layers containing more red blood cells forming a true thrombus.
Fates of thrombus : a cross section through a medium sized artery showing organization & the recanalization of the thrombus in these two slides. At the right the thrombus is replaced by area of granulation tissue ( organization)
This pulmonary thromboembolus is occluding the main pulmonary artery. (gross)
This is the microscopic appearance of a pulmonary embolus in a major pulmonary artery branch ( RBC, platelets, and fibrin forming lines of Zahn).
Diagnosis: pulmonary thromboembolism.
Here is a "saddle embolus" that bridges across the pulmonary artery from the heart, as it divides into right and left main pulmonary arteries.
A large wedge hemorrhagic area of infarction produced by a medium-sized thromboembolus to the lung.
Diagnosis: pulmonary infarction (hemorrhagic infarction)
A wedge-shaped firm pale area of coagulative necrosis (infarction) in the renal cortex of the kidney.Diagnosis : Coagulative necrosis of kidney (pale infarction)
Liver pathology
• A diagram illustrating the difference between acute & chronic viral hepatitisViral hepatitis: A large pink cell undergoing ballooning degeneration is seen below the right arrow. At a later stage a dying hepatocyte is seen shrinking down to form an eosinophilic “councilman body” below the arrow on the left.
Chronic Hepatitis, A mononuclear inflammatory cell infiltrate within the portal areas & hepatocytes which are undergoing necrosis,
Alcoholic hepatitis (acute alcoholic hepatitis): Mallory's hyaline is seen with neutrophils, necrosis of hepatocytes, collagen deposition and fatty changes
Globular red hyaline material within hepatocytes. This is Mallory's hyaline, also known as "alcoholic" hyaline because it is most often seen in conjunction with chronic alcoholism.
Fatty change (steatosis), liver is large yellow & greezy. Histology; lipid accumulates within the cytoplasm of hepatocytes, creating large clear vacuoles within cells. The nuclei in such cells are pushed to the periphery of the cell
Maconodular cirrhosis the liver is enlarged, firm & nodular. The size of nodule>3mm .
Cirrhosis: loss of architecture of the liver, regeneration nodules which are separated by fibrous tissues septa.
Secondary in the Liver, multiple irregular variable size nodules with central cavitations & necrosis
Bone Pathology
• Old case with advanced chronic osteomyelitis of the left mandible.
• (a) The massive affection of the left mandible demonstrates extraoral fistula• and scar formation.
• (b) Intraoral view of the same patient with large exposure of infected bone and sequestra.
• (c) Large sequester collected from surgery
A patient with a clinically extensive chronic osteomyelitis of the frontal region with multiple fistula and abscess formations.
Common presentation of fibrous dysplasia (FD) as asymptomatic swellings of peri-orbital area (a), zygoma (b), maxilla (c) and palatal surface of maxilla (d)
Fibrous dysplasia of left maxilla with involvement of both labial as well as palatal surface with visible left palatal bulge
FD showing irregular trabecullae (C-shaped or Chinese characters shaped trabaculae, (described as "Chinese letters“) which are usually coarse woven bone, are seen instead of well-organized lamellar bone. with compact stroma of interlacing collagen fibers
Buccal exostoses: Multiple bony nodular excrescences (growth) in the buccal aspect of .the maxilla
Facial asymmetry with apparent massive swelling involving the right side of the lower jaw measuring approx. 6.8 * 7.2 cm. The swelling was firm and non tender
Huge soft tissue mass obliterating the buccal, as well as the lingual sulcus pushing the tongue to the contra lateral side. The superior surface of the mass was ulcerated and eroded.
Dgx: Aneurysmal bone cyst of the mandible
Practical Hematology
College Of Dentistry /Third YearDr.Zainab Ahmed Al-selevani
Normal Blood Cells morphology
Normal neutrophil in the center of the field. The red cells show normal hemoglobin.
Iron deficiency anaemia
Significant hypochromia and microcytosis is seen, as well as moderate variation in size and shape of the red cells.Macrocytic Anaemia
An extremely large hypersegmented ( 8 lobes ) neutrophil, as are oval macrocytes.B-thalassaemia major
Hypochromic microcytes, target cells, a nucleated red blood cell (normoblast ).Sickle Cell Anaemia
A sickled cell is seen, as well as target cell in the center of the field. There is some anisocytosis and poikilocytosis.Acute leukaemia ( blasts )
This smear shows:Increased WBCs.
Blasts.Reduced platelets
Blast cells characteristics
Relatively large.High nuclear/cytoplasmic ratio.
Presence of nucleoli
Open chromatin
Chronic Lymphocytic Leukaemia ( CLL )
Increased WBCsAbsolute lymphocytosis.
Lymphocytes are mature looking with frequent torn cells (smear cells).
Chronic Myeloid Leukaemia ( CML )
Increased WBC count.Granulocytes at different stages of maturation .
Basophilia.
Practical respiratory
Systemطب الاسنان
This inverted papilloma of the nose is a benign but locally aggressive neoplasm that can also occur in the paranasal sinuses. The proliferating squamous epithelium tends to "invert" inward into the stroma so that islands of squamous mucosa appear below the surface, as seen here
Nasal mass with edematous stroma with chronic inflammatory cell infiltrate ( mainly eosinophils) covered by ciliated columnar epitheliumallergic nasal polyp
A normal lung microscopically
An example of bronchopneumonia with multiple areas of consolidation (lobular pneumonia)
A lobar pneumonia with firm brownish-tan consolidation of the entire left upper lobe, which is confined by fissure line.
Bronchopneumonia with patchy area of alveoli filled with inflammatory cells with congestion of alveolar wall.
Viral pneumonia: Interstitial mononuclear cells mainly lymphocytic cells (interstitial pneumonia)
Bronchial asthma sub mucosal smooth muscle hypertrophy, basement membrane thickening, inflammatory cell infiltration rich in eosinophils with mucus collection in lumen, vascular congestion
Destructed & dilated large airways form a honeycomb pattern in Bronchiectasis
Bronchiectasis: dilated bronchus with inflammation & destruction of the wall
Bullous emphysema involving all lobes of the lung (panlobular emphysema). This carry risk of rupture & pneumothorax
Destruction of alveolar wall & dilatation of air spaces seen in emphysema
A pleural effusion ,the collected fluid within the pleural cavity is serosanguinous (serous & blood) with collapse of both lungs
Yellowish tan fluid collected in the right pleural cavity it can be empyema or chylothorax.
Centrally located irregular firm to solid whitish-gray mass compressing left bronchus with area of hemorrhage.
Diagnosis: bronchogenic carcinoma, mostly Squamous cell carcinoma
Tumor has a soft, lobulated, white to tan appearance, obstructing the main bronchus to left lung so that the distal lung is collapsed. Small cell carcinomas are very aggressive and often metastasize widely
Small cell carcinoma with small dark blue cells packet in sheets
Solitary irregular yellowish-tan firm mass at periphery of lower left lung.
Diagnosis: Bronchogenic carcinoma, mostly adenocarcinomaPracticalLympho-Reticular System
Non neoplastic lymphadenopathyLN is tender ,congested with sinus cattarh. Suppuration may occur.
Chronic Lymphadenitis (Reactive hyperplasia) follicles of different size & shapes with prominent germinal center & prominent mantle zone( B-zone)
Hodgkin`s lymphoma
Grossly : lymph node is enlarged, firm discrete with homogenous ,potato- like cut surface.Hodgkin’s Lymphoma, Reed-Sternberg Cells: The conventional definition of Hodgkin’s lymphoma requires the presence of Reed-Sternberg cells (many are seen in this image) in a characteristic background infiltrate composed of eosinophils, lymphocytes, plasma cells, and histiocytes. It lacks the monomorphic appearance of non-Hodgkin’s lymphomas
Hodgkin lymphoma, Reed-Sternberg cell, (Large cell with abundant eosinophilic cytoplasm, large bilobated, or binucleated vesicular nuclei, & prominent eosinophilic large nucleoli (mirror-image or owl-eye apopearance) present in a reactive background
Non hodgkin lymphoma , loss of lymph node architecture, with monotonous diffuse proliferation of lymphoid cells with prominent mitotic figures
Normal Blood Cells morphology
Normal neutrophil in the center of the field. The red cells show normal hemoglobinization.Iron deficiency anaemia
Significant hypochromia and microcytosis is seen, as well as moderate variation in size and shape of the red cells.Macrocytic Anaemia
An extremely large hypersegmented ( 8 lobes ) neutrophil, as are oval macrocytes.B-thalassaemia major
Hypochromic microcytes, target cells, a nucleated red blood cell (normoblast ).Sickle Cell Anaemia
A sickled cell is seen, as is a classic target cell in the center of the field. There is some anisocytosis and poikilocytosis, as well as some faint basophilic stippling in one cell.HereditarySpherocytosis
A normal lymphocyte and many spherocytic red cells are seen
Acute leukaemia ( blasts )
This smear shows:Increased WBCs.
Blastaemia.Reduced platelets
Blast cells characteristics
Relatively large.High nuclear/cytoplasmic ratio.
Presence of nucleoli
Open chromatin
Chronic Lymphocytic Leukaemia ( CLL )
Increased WBCsAbsolute lymphocytosis.
Lymphocytes are mature looking with frequent torn cells (smear cells), note the presence of a prolymphocyte
Chronic Myeloid Leukaemia ( CML )
Increased WBC count.
Granulocytes at different stages of maturation .
Basophilia.
Multiple Myeloma1. BM infiltration by Plasma cells of different stages of maturation. One shows mitosis (arrow).